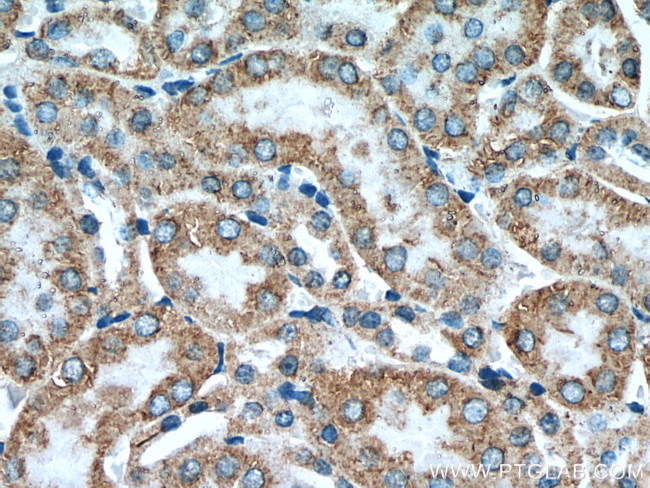
KIAA1279 Antibody in Immunohistochemistry (Paraffin) (IHC (P))
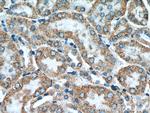
KIAA1279 Antibody in Immunohistochemistry (Paraffin) (IHC (P))

Search
Proteintech
KIAA1279 Polyclonal Antibody
{{$productOrderCtrl.translations['antibody.pdp.commerceCard.promotion.promotions']}}
{{$productOrderCtrl.translations['antibody.pdp.commerceCard.promotion.viewpromo']}}
{{$productOrderCtrl.translations['antibody.pdp.commerceCard.promotion.promocode']}}: {{promo.promoCode}} {{promo.promoTitle}} {{promo.promoDescription}}. {{$productOrderCtrl.translations['antibody.pdp.commerceCard.promotion.learnmore']}}
产品信息
25653-1-AP
种属反应
已发表种属
宿主/亚型
分类
类型
抗原
偶联物
形式
浓度
规格
纯化类型
保存液
内含物
保存条件
运输条件
产品详细信息
Immunogen sequence: CLSAANVIF GQTGKISATE DTPEAEGEVP ELYHQRKGEI ARCWIKYCLT LMQNAQLSMQ DNIGELDLDK QSELRALRKK ELDEEESIRK KAVQFGTGEL CDAISAVEEK VSYLRPLDFE EARELFLLGQ HYVFEAKEFF QIDGYVTDHI EVVQDHSALF KVLAFFETDM ERRCKMHKRR IAMLEPLTVD LNPQYYLLVN RQIQFEIAHA YYDMMDLKVA IADRLRDPDS HIVKKINNLN KSALKYYQLF LDSLRDPNKV FPEHIGEDVL RPAMLAKFRV ARLYGKIITA DPKKELENLA TSLEHYKFIV DYCEKHPEAA QEIEVELELS KEMVSLLPTK MERFRTKMAL T (272-621 aa encoded by BC012180)
靶标信息
Required for neuronal development and differentiation. Required for organization of axonal microtubules, and axonal outgrowth and maintenance during peripheral and central nervous system development. [UniProt]
仅用于科研。不用于诊断过程。未经明确授权不得转售。
生物信息学
蛋白别名: KIF-binding protein; KIF1 binding protein; KIF1-binding protein; kinesin binding protein; Kinesin family binding protein; mutant KIF1 binding protein; unnamed protein product
基因别名: 0710007C18Rik; 2510003E04Rik; KBP; KIAA1279; KIF1BP; KIFBP; mKIAA1279; TTC20
UniProt ID: (Human) Q96EK5, (Mouse) Q6ZPU9
Entrez Gene ID: (Human) 26128, (Mouse) 72320